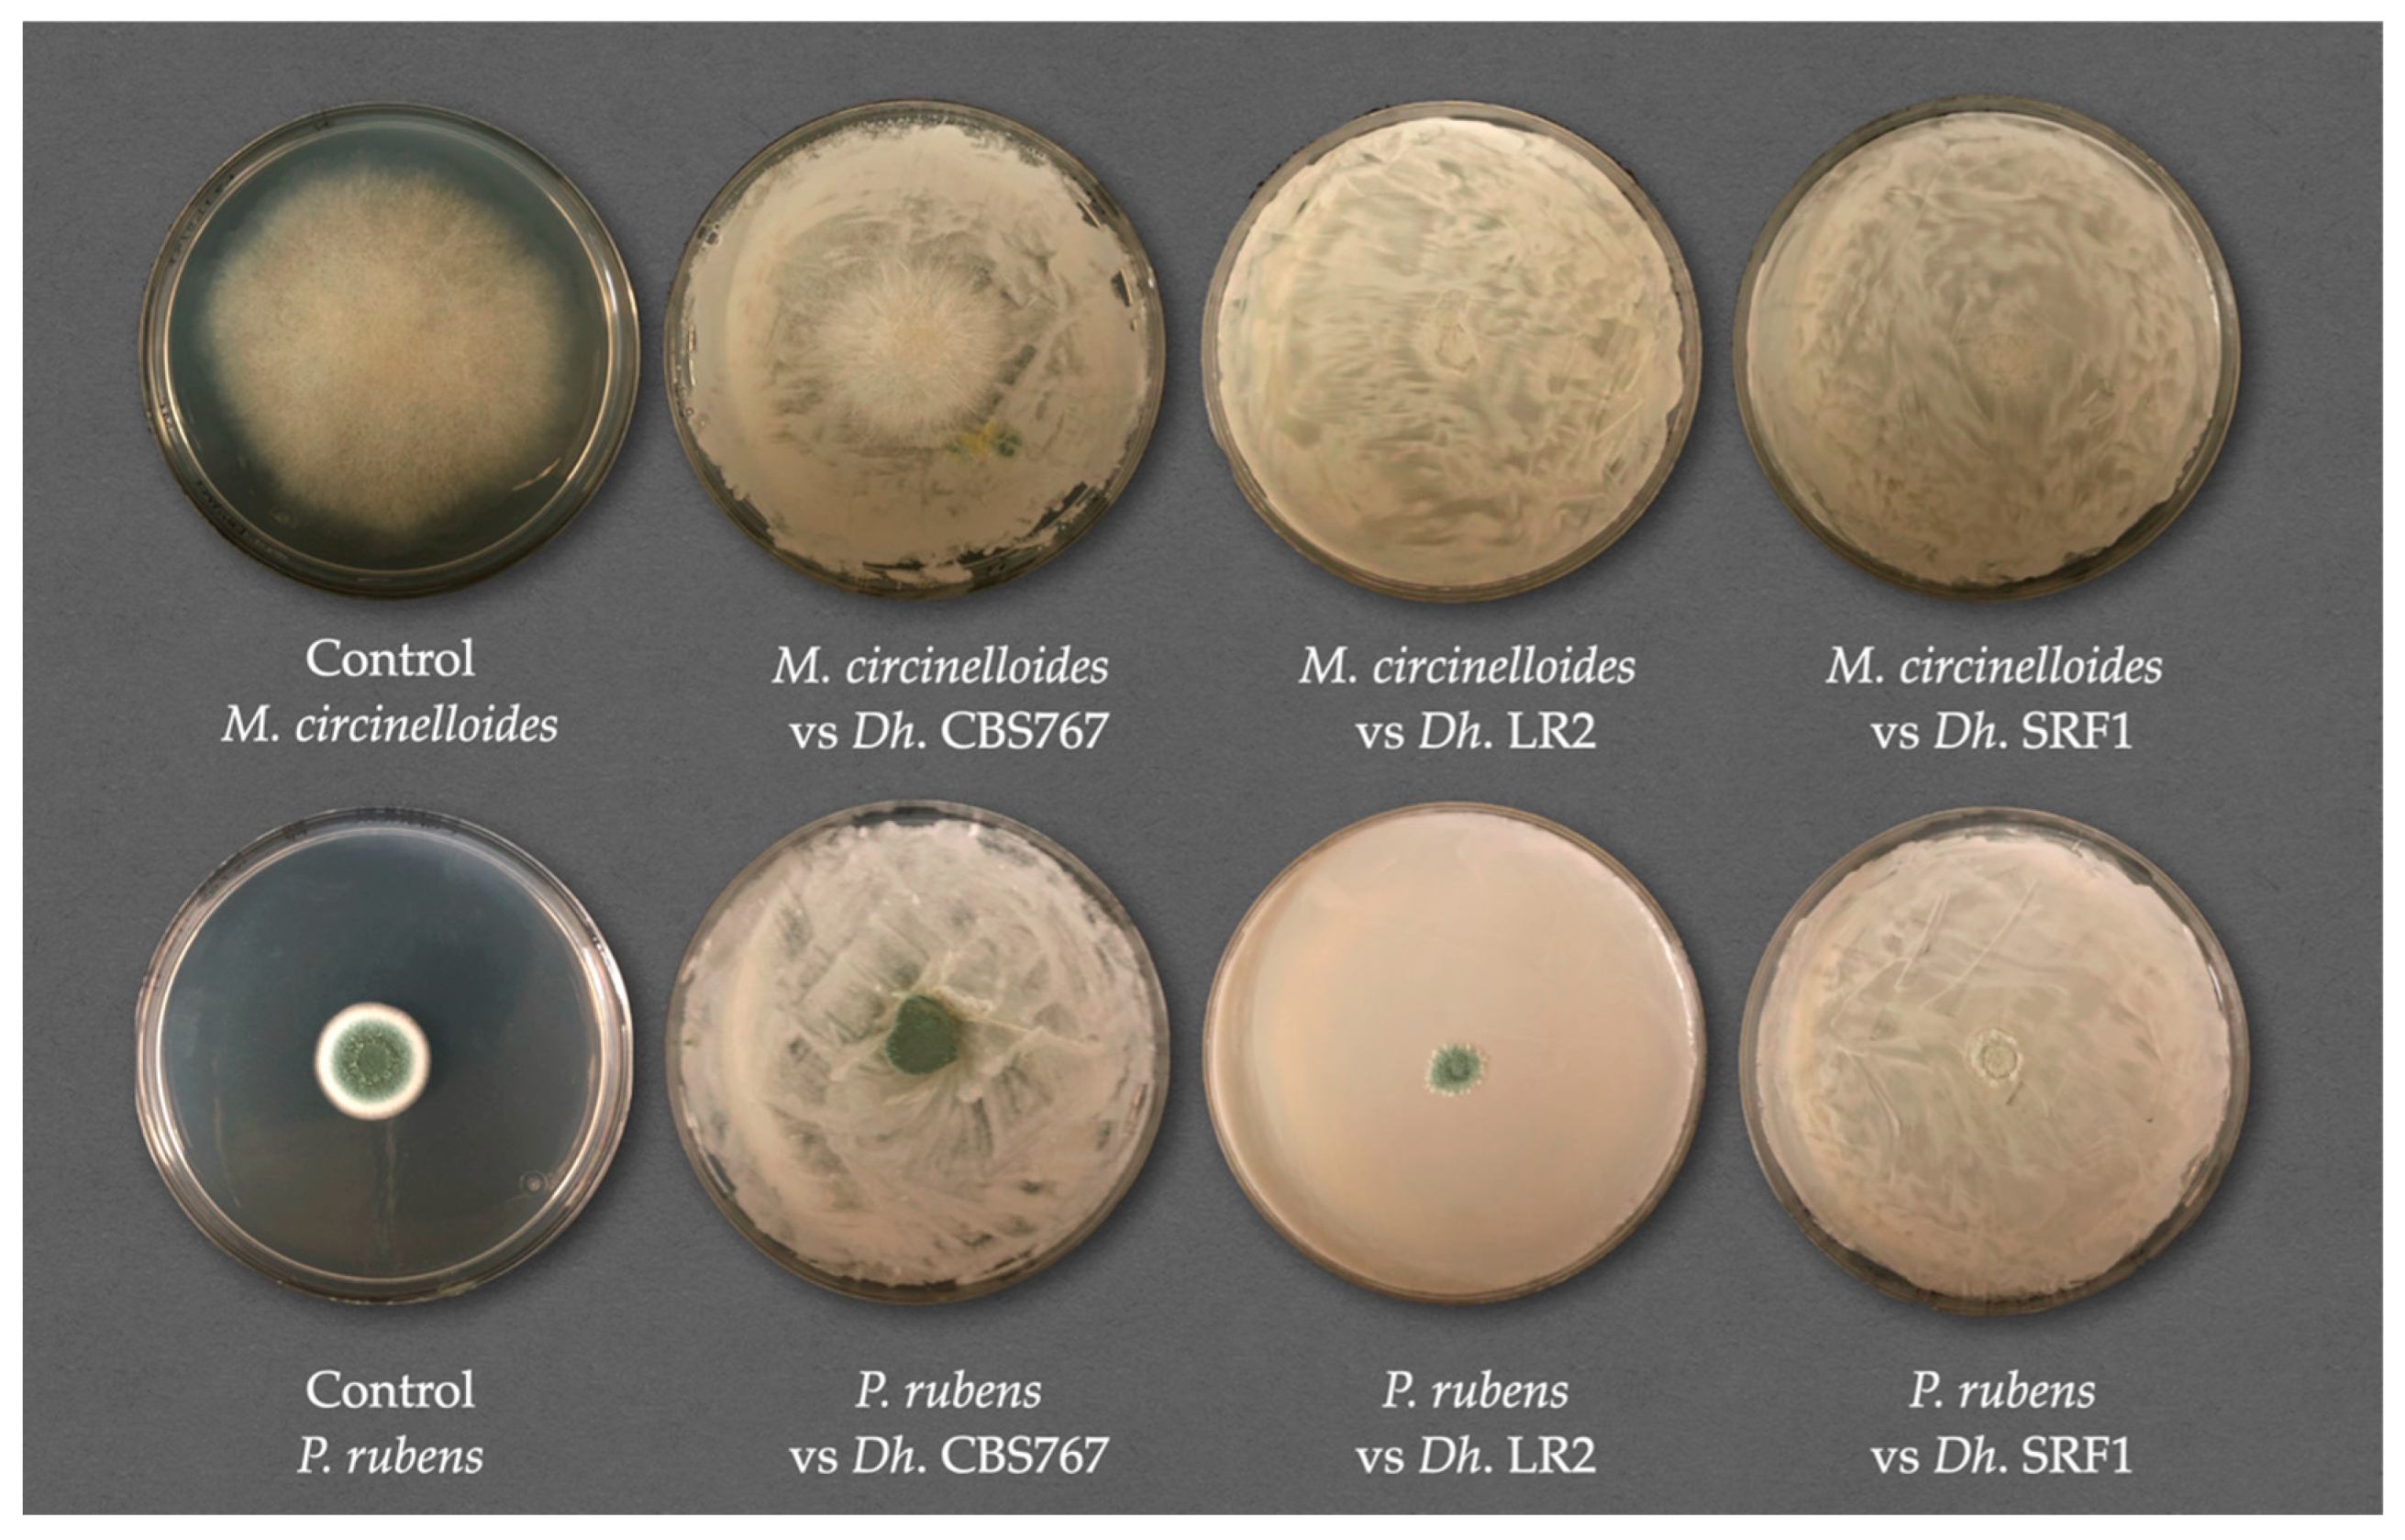
Jof 11 00242 g003
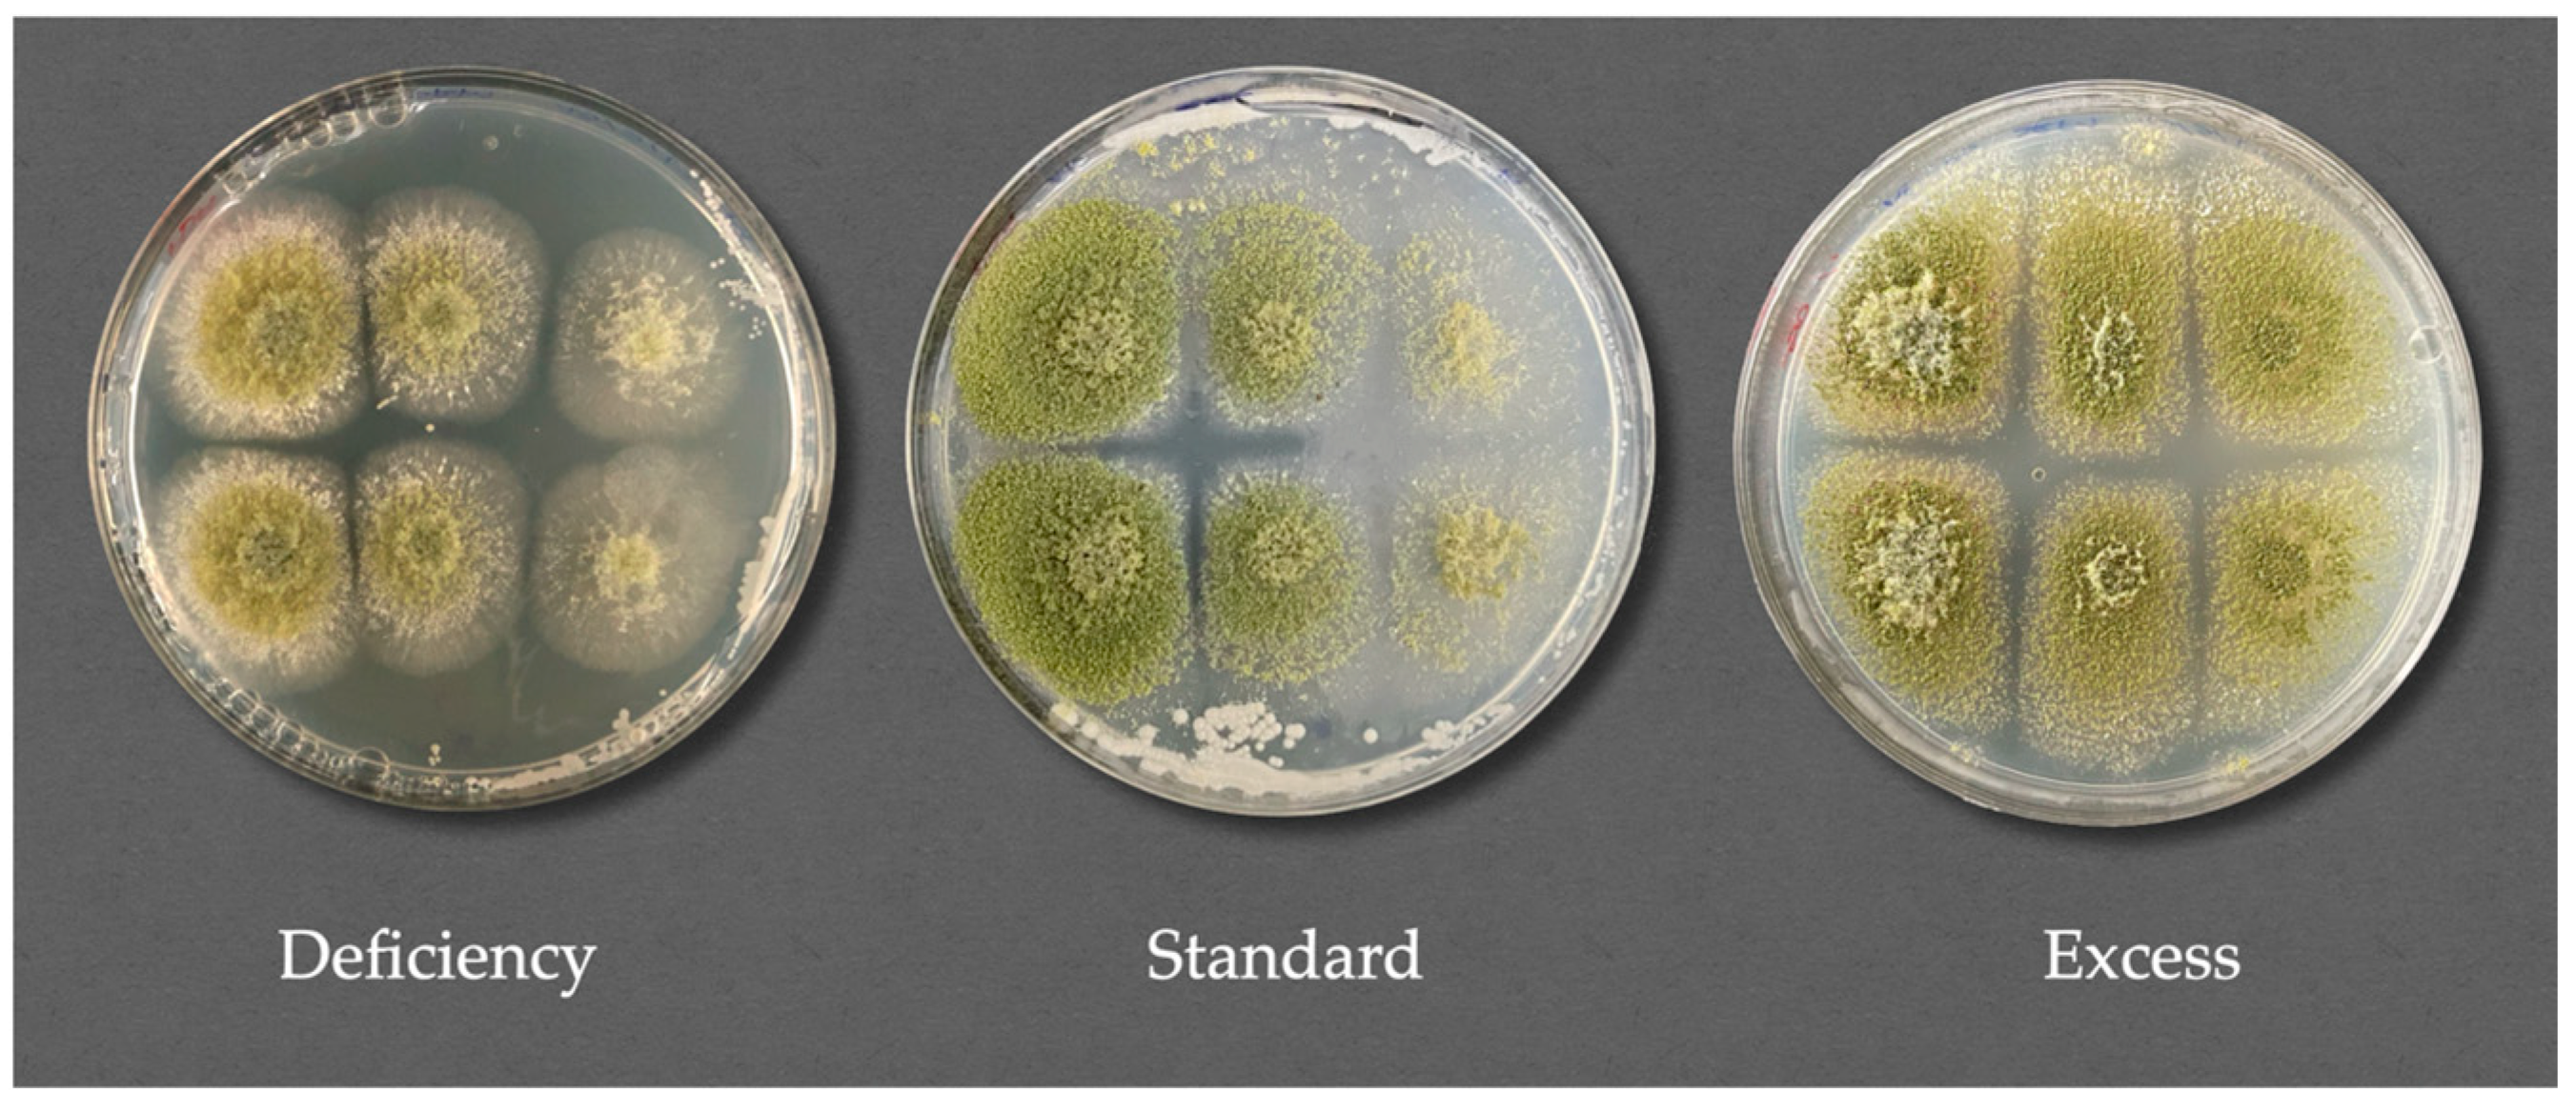
Jof 11 00242 g006

Evaluating the Role of Nutrient Competition in Debaryomyces hansenii Biocontrol Activity Against Spoilage Molds in the Meat Industry
Abstract
1. Introduction
2. Materials and Methods
2.1. Strains and Culture Conditions
2.2. Isolation of Filamentous Fungi from Contaminated Samples
2.3. Identification of Filamentous Fungal Isolates
2.4. Fungal Inhibition Assay in the Presence of D. hansenii Strains
2.5. Fungal Inhibition Assay After D. hansenii Interaction. Inhibition Activity Through Semipermeable Membranes
2.5.1. Nutrient Competition Mechanism Assay
2.5.2. Inhibition of the Fungal Reproductive System. Spore Counting
2.6. Data Quantification and Statistical Analysis
3. Results
3.1. Isolation and Identification of Filamentous Fungi from Contaminated Samples
3.2. Fungal Inhibition Assay in the Presence of D. hansenii Strains
3.3. Direct Versus Indirect Contact: Antifungal Assessment of D. hansenii Against Various Molds
3.4. Inhibition of Molds Post D. hansenii Action: Inhibition Activity Through Semipermeable Membranes
3.4.1. Nutrient Competition Mechanism Assay
3.4.2. Specific Mold Species Inhibition Under Different Nutrient Concentration Conditions
3.4.3. Inhibition of the Reproductive Fungal System. Spore Counting
3.4.4. Integrative Analysis of Spore Production Relative to Mycelial Expansion
3.4.5. Specific Mold Species Spore Production Affection by D. hansenii in Modified Nutrient Concentration Conditions: Relative to Mycelial Expansion
3.4.6. Quantitative Assessment of Spore Production in Defined Extraction Zones
3.4.7. Specific Mold Species Spore Production Affection by D. hansenii Under Modified Nutrient Concentration Conditions: Defined Extraction Zones
4. Discussion
5. Conclusions
Supplementary Materials
Author Contributions
Funding
Institutional Review Board Statement
Informed Consent Statement
Data Availability Statement
Acknowledgments
Conflicts of Interest
References
- Van Loo, E.J.; Ricke, S.C.; O’bryan, C.A.; Johnson, M.G. Historical and Current Perspectives on Organic Meat Production. In Organic Meat Production and Processing; Ricke, S.C., Van Loo, E.J., Johnson, M.G., O’Bryan, C.A., Eds.; Wiley: Hoboken, NJ, USA, 2012; pp. 1–9. [Google Scholar]
- Gokoglu, N. Novel Natural Food Preservatives and Applications in Seafood Preservation: A Review. J. Sci. Food Agric. 2019, 99, 2068–2077. [Google Scholar] [CrossRef]
- Novais, C.; Molina, A.K.; Abreu, R.M.V.; Santo-Buelga, C.; Ferreira, I.C.F.R.; Pereira, C.; Barros, L. Natural Food Colorants and Preservatives: A Review, a Demand, and a Challenge. J. Agric. Food Chem. 2022, 70, 2789–2805. [Google Scholar] [CrossRef] [PubMed]
- Avis, T.J.; Belanger, R.R. Mechanisms and Means of Detection of Biocontrol Activity of Pseudozyma Yeasts against Plant-Pathogenic Fungi. FEMS Yeast Res. 2002, 2, 5–8. [Google Scholar] [CrossRef] [PubMed]
- Liu, J.; Sui, Y.; Wisniewski, M.; Droby, S.; Liu, Y. Review: Utilization of Antagonistic Yeasts to Manage Postharvest Fungal Diseases of Fruit. Int. J. Food Microbiol. 2013, 167, 153–160. [Google Scholar] [CrossRef] [PubMed]
- Sipiczki, M. Identification of Antagonistic Yeasts as Potential Biocontrol Agents: Diverse Criteria and Strategies. Int. J. Food Microbiol. 2023, 406, 110360. [Google Scholar] [CrossRef]
- Agirman, B.; Carsanba, E.; Settanni, L.; Erten, H. Exploring Yeast-based Microbial Interactions: The next Frontier in Postharvest Biocontrol. Yeast 2023, 40, 457–475. [Google Scholar] [CrossRef]
- Medina-Córdova, N.; López-Aguilar, R.; Ascencio, F.; Castellanos, T.; Campa-Córdova, A.I.; Angulo, C. Biocontrol Activity of the Marine Yeast Debaryomyces hansenii against Phytopathogenic Fungi and Its Ability to Inhibit Mycotoxins Production in Maize Grain (Zea mays L.). Biol. Control 2016, 97, 70–79. [Google Scholar] [CrossRef]
- Shwaiki, L.N.; Arendt, E.K.; Lynch, K.M.; Thery, T.L.C. Inhibitory Effect of Four Novel Synthetic Peptides on Food Spoilage Yeasts. Int. J. Food Microbiol. 2019, 300, 43–52. [Google Scholar] [CrossRef]
- Chacón-Navarrete, H.; Ruiz-Pérez, F.; Ruiz-Castilla, F.J.; Ramos, J. Exploring Biocontrol of Unwanted Fungi by Autochthonous Debaryomyces hansenii Strains Isolated from Dry Meat Products. J. Fungi 2022, 8, 873. [Google Scholar] [CrossRef]
- Chacón-Navarrete, H.; Gómez, M.; Cardador, M.J.; Salatti-Dorado, J.Á.; Pérez-Cacho, P.R.; Roldán-Casas, J.Á.; Arce, L.; Galán-Soldevilla, H.; López, B.; Ramos, J.; et al. The Antimycotic Potential of Debaryomyces hansenii LRC2 on Iberian Pork Loins with Low Concentration Preservatives. Food Control 2024, 165, 110632. [Google Scholar] [CrossRef]
- Butler, G.; Rasmussen, M.D.; Lin, M.F.; Santos, M.A.S.; Sakthikumar, S.; Munro, C.A.; Rheinbay, E.; Grabherr, M.; Forche, A.; Reedy, J.L.; et al. Evolution of Pathogenicity and Sexual Reproduction in Eight Candida Genomes. Nature 2009, 459, 657–662. [Google Scholar] [CrossRef] [PubMed]
- Gancedo, C.; Serrano, R. Energy-Yielding Metabolism, 2nd ed.; The Yeasts; Academic Press: London, UK, 1989; Volume 3, pp. 205–259. [Google Scholar]
- Sugita, T.; Nakase, T. Non-Universal Usage of the Leucine CUG Codon and the Molecular Phylogeny of the Genus Candida. Syst. Appl. Microbiol. 1999, 22, 79–86. [Google Scholar] [CrossRef]
- Dujon, B.; Sherman, D.; Fischer, G.; Durrens, P.; Casaregola, S.; Lafontaine, I.; De Montigny, J.; Marck, C.; Neuvéglise, C.; Talla, E.; et al. Genome Evolution in Yeasts. Nature 2004, 430, 35–44. [Google Scholar] [CrossRef]
- Breuer, U.; Harms, H. Debaryomyces Hansenii—An Extremophilic Yeast with Biotechnological Potential. Yeast 2006, 23, 415–437. [Google Scholar] [CrossRef] [PubMed]
- Aquilanti, L.; Santarelli, S.; Silvestri, G.; Osimani, A.; Petruzzelli, A.; Clementi, F. The Microbial Ecology of a Typical Italian Salami during Its Natural Fermentation. Int. J. Food Microbiol. 2007, 120, 136–145. [Google Scholar] [CrossRef] [PubMed]
- Prista, C.; Michán, C.; Miranda, I.M.; Ramos, J. The Halotolerant Debaryomyces hansenii, the Cinderella of Non-conventional Yeasts. Yeast 2016, 33, 523–533. [Google Scholar] [CrossRef]
- Virgili, R.; Simoncini, N.; Toscani, T.; Camardo Leggieri, M.; Formenti, S.; Battilani, P. Biocontrol of Penicillium nordicum Growth and Ochratoxin A Production by Native Yeasts of Dry Cured Ham. Toxins 2012, 4, 68–82. [Google Scholar] [CrossRef]
- Andrade, M.J.; Thorsen, L.; Rodríguez, A.; Córdoba, J.J.; Jespersen, L. Inhibition of Ochratoxigenic Moulds by Debaryomyces hansenii Strains for Biopreservation of Dry-Cured Meat Products. Int. J. Food Microbiol. 2014, 170, 70–77. [Google Scholar] [CrossRef]
- Çorbacı, C.; Uçar, F.B. Purification, Characterization and in Vivo Biocontrol Efficiency of Killer Toxins from Debaryomyces hansenii Strains. Int. J. Biol. Macromol. 2018, 119, 1077–1082. [Google Scholar] [CrossRef]
- Spadaro, D.; Droby, S. Development of Biocontrol Products for Postharvest Diseases of Fruit: The Importance of Elucidating the Mechanisms of Action of Yeast Antagonists. Trends Food Sci. Technol. 2016, 47, 39–49. [Google Scholar] [CrossRef]
- Freimoser, F.M.; Rueda-Mejia, M.P.; Tilocca, B.; Migheli, Q. Biocontrol Yeasts: Mechanisms and Applications. World J. Microbiol. Biotechnol. 2019, 35, 154. [Google Scholar] [CrossRef]
- Simoncini, N.; Virgili, R.; Spadola, G.; Battilani, P. Autochthonous Yeasts as Potential Biocontrol Agents in Dry-Cured Meat Products. Food Control 2014, 46, 160–167. [Google Scholar] [CrossRef]
- Pleadin, J.; Frece, J.; Markov, K. Mycotoxins in Food and Feed. In Advances in Food and Nutrition Research; Elsevier: Amsterdam, The Netherlands, 2019; Volume 89, pp. 297–345. ISBN 978-0-12-817171-4. [Google Scholar]
- Ritz, K. Growth Responses of Some Soil Fungi to Spatially Heterogeneous Nutrients. FEMS Microbiol. Ecol. 1995, 16, 269–280. [Google Scholar] [CrossRef]
- Crowther, T.W.; Boddy, L.; Jones, T.H. Outcomes of Fungal Interactions Are Determined by Soil Invertebrate Grazers: Grazers Alter Fungal Community. Ecol. Lett. 2011, 14, 1134–1142. [Google Scholar] [CrossRef] [PubMed]
- Choudhury, M.; Trevelyan, P.; Boswell, G.A. Mathematical Model of Nutrient Influence on Fungal Competition. J. Theor. Biol. 2018, 438, 9–20. [Google Scholar] [CrossRef] [PubMed]
- Guo, Y.; He, Y.; Wu, P.; Wu, B.; Lin, Y.; He, M.; Han, X.; Xia, T.; Shen, K.; Kang, L.; et al. The Interspecific Competition Presents Greater Nutrient Facilitation Compared with Intraspecific Competition through AM Fungi Interacting with Litter for Two Host Plants in Karst Soil. J. Plant Ecol. 2022, 15, 399–412. [Google Scholar] [CrossRef]
- Hilber-Bodmer, M.; Schmid, M.; Ahrens, C.H.; Freimoser, F.M. Competition Assays and Physiological Experiments of Soil and Phyllosphere Yeasts Identify Candida subhashii as a Novel Antagonist of Filamentous Fungi. BMC Microbiol. 2017, 17, 4. [Google Scholar] [CrossRef]
- Ramos-Moreno, L.; Ruiz-Castilla, F.J.; Bravo, C.; Martínez, E.; Menéndez, M.; Dios-Palomares, R.; Ramos, J. Inoculation with a Terroir Selected Debaryomyces Hansenii Strain Changes Physico-Chemical Characteristics of Iberian Cured Pork Loin. Meat Sci. 2019, 157, 107875. [Google Scholar] [CrossRef]
- Rivas-Garcia, T.; Murillo-Amador, B.; Nieto-Garibay, A.; Rincon-Enriquez, G.; Chiquito-Contreras, R.G.; Hernandez-Montiel, L.G. Enhanced Biocontrol of Fruit Rot on Muskmelon by Combination Treatment with Marine Debaryomyces hansenii and Stenotrophomonas rhizophila and Their Potential Modes of Action. Postharvest Biol. Technol. 2019, 151, 61–67. [Google Scholar] [CrossRef]
- Núñez, F.; Lara, M.S.; Peromingo, B.; Delgado, J.; Sánchez-Montero, L.; Andrade, M.J. Selection and Evaluation of Debaryomyces hansenii Isolates as Potential Bioprotective Agents against Toxigenic Penicillia in Dry-Fermented Sausages. Food Microbiol. 2015, 46, 114–120. [Google Scholar] [CrossRef]
- Hernandez-Montiel, L.G.; Gutierrez-Perez, E.D.; Murillo-Amador, B.; Vero, S.; Chiquito-Contreras, R.G.; Rincon-Enriquez, G. Mechanisms Employed by Debaryomyces hansenii in Biological Control of Anthracnose Disease on Papaya Fruit. Postharvest Biol. Technol. 2018, 139, 31–37. [Google Scholar] [CrossRef]
- Droby, S.; Chalutz, E.; Wilson, C.L.; Wisniewski, M. Characterization of the Biocontrol Activity of Debaryomyces hansenii in the Control of Penicillium Digitatum on Grapefruit. Can. J. Microbiol. 1989, 35, 794–800. [Google Scholar] [CrossRef]
- Álvarez, M.; Núñez, F.; Delgado, J.; Andrade, M.J.; Rodríguez, M.; Rodríguez, A. Competitiveness of Three Biocontrol Candidates against Ochratoxigenic Penicillium nordicum under Dry-Cured Meat Environmental and Nutritional Conditions. Fungal Biol. 2021, 125, 134–142. [Google Scholar] [CrossRef]
- Ramos, J.; Melero, Y.; Ramos-Moreno, L.; Michán, C.; Cabezas, L. Debaryomyces Hansenii Strains from Valle De Los Pedroches Iberian Dry Meat Products: Isolation, Identification, Characterization, and Selection for Starter Cultures. J. Microbiol. Biotechnol. 2017, 27, 1576–1585. [Google Scholar] [CrossRef]
- Prista, C.; Almagro, A.; Loureiro-Dias, M.C.; Ramos, J. Physiological Basis for the High Salt Tolerance of Debaryomyces hansenii. Appl. Environ. Microbiol. 1997, 63, 4005–4009. [Google Scholar] [CrossRef] [PubMed]
- Conlon, B.H.; Schmidt, S.; Shik, J.Z. Orthogonal Protocols for DNA Extraction from Filamentous Fungi. STAR Protoc. 2022, 3, 101126. [Google Scholar] [CrossRef]
- Usyk, M.; Zolnik, C.P.; Patel, H.; Levi, M.H.; Burk, R.D. Novel ITS1 Fungal Primers for Characterization of the Mycobiome. mSphere 2017, 2, e00488-17. [Google Scholar] [CrossRef] [PubMed]
- Velle, L. Osmosis. J. Biol. Edu. 2002, 36, 145. [Google Scholar] [CrossRef]
- Rundberget, T.; Skaar, I.; Flåøyen, A. The Presence of Penicillium and Penicillium Mycotoxins in Food Wastes. Int. J. Food Microbiol. 2004, 90, 181–188. [Google Scholar] [CrossRef]
- Snyder, A.B.; Churey, J.J.; Worobo, R.W. Characterization and Control of Mucor circinelloides Spoilage in Yogurt. Int. J. Food Microbiol. 2016, 228, 14–21. [Google Scholar] [CrossRef]
- Tai, B.; Chang, J.; Liu, Y.; Xing, F. Recent Progress of the Effect of Environmental Factors on Aspergillus flavus Growth and Aflatoxins Production on Foods. Food Qual. Saf. 2020, 4, 21–28. [Google Scholar] [CrossRef]
- Kure, C.F.; Skaar, I. The Fungal Problem in Cheese Industry. Curr. Opin. Food Sci. 2019, 29, 14–19. [Google Scholar] [CrossRef]
- Patsoukis, N.; Georgiou, C.D. Effect of Sulfite–Hydrosulfite and Nitrite on Thiol Redox State, Oxidative Stress and Sclerotial Differentiation of Filamentous Phytopathogenic Fungi. Pestic. Biochem. Physiol. 2007, 88, 226–235. [Google Scholar] [CrossRef]
- Al-Qaysi, S.A.S.; Al-Haideri, H.; Thabit, Z.A.; Al-Kubaisy, W.H.A.A.; Ibrahim, J.A.A. Production, Characterization, and Antimicrobial Activity of Mycocin Produced by Debaryomyces hansenii DSMZ70238. Int. J. Microbiol. 2017, 2017, 2605382. [Google Scholar] [CrossRef]
- Delgado, J.; Rodríguez, A.; García, A.; Núñez, F.; Asensio, M.A. Inhibitory Effect of PgAFP and Protective Cultures on Aspergillus parasiticus Growth and Aflatoxins Production on Dry-Fermented Sausage and Cheese. Microorganisms 2018, 6, 69. [Google Scholar] [CrossRef]
- Lee, S.C.; Billmyre, R.B.; Li, A.; Carson, S.; Sykes, S.M.; Huh, E.Y.; Mieczkowski, P.; Ko, D.C.; Cuomo, C.A.; Heitman, J. Analysis of a Food-Borne Fungal Pathogen Outbreak: Virulence and Genome of a Mucor circinelloides Isolate from Yogurt. mBio 2014, 5, e01390-14. [Google Scholar] [CrossRef]

| NaCl (Table Salt) | Nitrites | Condition Name | Reduction Percentage |
|---|---|---|---|
| 25 | 5.0 | 25/5.0 | 0% (Commercial sample) |
| 25 | 4.5 | 25/4.5 | 10% |
| 25 | 4.0 | 25/4.0 | 20% |
| 25 | 3.5 | 25/3.5 | 30% |
| 20 | 5.0 | 20/5.0 | 20% |
| Isolate | Identification | Similarity |
|---|---|---|
| HSC30 | Penicillium crustosum | 100.00% |
| HPDA3 | Penicillium echinulatum | 100.00% |
| HPDA10 | Penicillium rubens | 100.00% |
| HSC34 | Mucor racemosus | 100.00% |
| HPDA14 | Penicillium echinulatum | 100.00% |
| HPDA7 | Penicillium crustosum | 100.00% |
| HYPD3 | Mucor circinelloides f. circinelloides | 100.00% |
| HSC31 | Aspergillus flavus | 99.46% |
| Condition Name | Presence Percentage (%) | |||||
|---|---|---|---|---|---|---|
| Bacteria | Yeast | Mold | ||||
| CL | SL | CL | SL | CL | SL | |
| 25/5.0 | 45.00 | 50.00 | 50.00 | 62.50 | 57.14 | 57.14 |
| 25/4.5 | 40.00 | 50.00 | 37.50 | 37.50 | 71.43 | 71.43 |
| 25/4.0 | 50.00 | 60.00 | 62.50 | 50.00 | 71.43 | 71.43 |
| 25/3.5 | 55.00 | 55.00 | 50.00 | 50.00 | 85.71 | 85.71 |
| 20/5.0 | 65.00 | 60.00 | 50.00 | 50.00 | 42.86 | 71.43 |
Disclaimer/Publisher’s Note: The statements, opinions and data contained in all publications are solely those of the individual author(s) and contributor(s) and not of MDPI and/or the editor(s). MDPI and/or the editor(s) disclaim responsibility for any injury to people or property resulting from any ideas, methods, instructions or products referred to in the content. |
© 2025 by the authors. Licensee MDPI, Basel, Switzerland. This article is an open access article distributed under the terms and conditions of the Creative Commons Attribution (CC BY) license (https://creativecommons.org/licenses/by/4.0/).
Share and Cite
Chacón-Navarrete, H.; García-Álvarez de Toledo, I.; Ramos, J.; Ruiz-Castilla, F.J. Evaluating the Role of Nutrient Competition in Debaryomyces hansenii Biocontrol Activity Against Spoilage Molds in the Meat Industry. J. Fungi 2025, 11, 242. https://doi.org/10.3390/jof11040242
Chacón-Navarrete H, García-Álvarez de Toledo I, Ramos J, Ruiz-Castilla FJ. Evaluating the Role of Nutrient Competition in Debaryomyces hansenii Biocontrol Activity Against Spoilage Molds in the Meat Industry. Journal of Fungi. 2025; 11(4):242. https://doi.org/10.3390/jof11040242
Chicago/Turabian StyleChacón-Navarrete, Helena, Ignacio García-Álvarez de Toledo, José Ramos, and Francisco Javier Ruiz-Castilla. 2025. "Evaluating the Role of Nutrient Competition in Debaryomyces hansenii Biocontrol Activity Against Spoilage Molds in the Meat Industry" Journal of Fungi 11, no. 4: 242. https://doi.org/10.3390/jof11040242
APA StyleChacón-Navarrete, H., García-Álvarez de Toledo, I., Ramos, J., & Ruiz-Castilla, F. J. (2025). Evaluating the Role of Nutrient Competition in Debaryomyces hansenii Biocontrol Activity Against Spoilage Molds in the Meat Industry. Journal of Fungi, 11(4), 242. https://doi.org/10.3390/jof11040242

